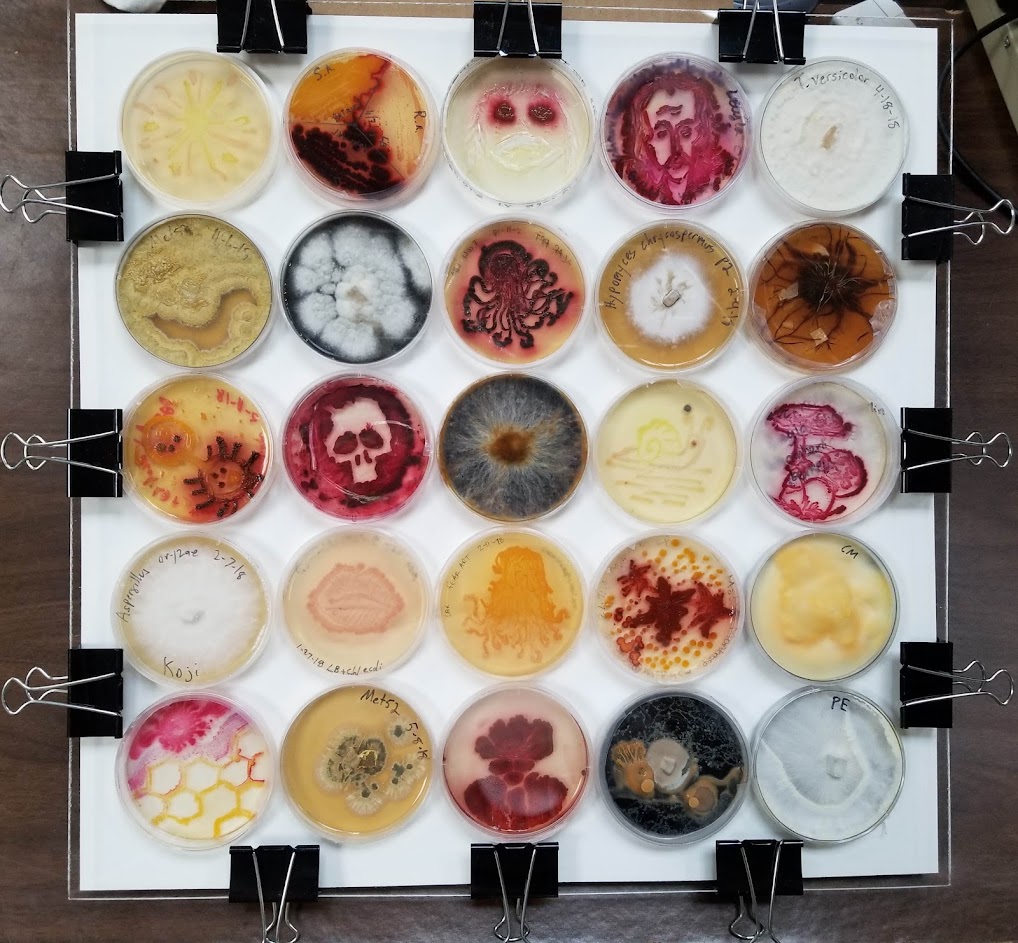
width=

Ai Digital Biology
News Digest #235 – The lab is getting smarter, cheaper, and more agile, Free Genes Project makes DNA freely available to the world (sponsored by Labcyte)
Sep 2, 2018

Hi all,The lab is getting smarter, cheaper, and more agile. In case you missed our Deep Dive with Amyris and Labcyte, you can watch it here to learn how you can build a faster, cheaper, and more eco-friendly automation pipeline, build more strains, and reduce your consumables. Check out this article that explores how acoustic dispensing will become an instrumental technology in synthetic biology. And, learn how the open-access software and protocols of the Opentrons OT-2 robot are enabling the BioBricks Foundation Free Genes Project.


Moving liquids by sound waves means unprecedented precision, miniaturization and control. Watch the SynBioBeta video: Mark Fischer-Colbrie explains the applications of this technology in drug discovery, genomics, and precision medicine.
Labcyte is hosting two workshops and a lunch on October 4th as part of Synthetic Biology Week: you can learn how cell-free transcription-translation systems are a versatile platform for protein production within synthetic biology, and how the Echo Liquid Handler can reduce your experimental cycle time.Join us on September 30th for a screening of the thriller GATTACA, and Una Ryan for a gallery showing of her artwork that combines images of the very small under the microscope and the very big from satellite imagery.Don’t miss the Counter Culture Biohackers, Open Science & Community Labs for a presentation on international collaborations such as Open Insulin, Real Vegan Cheese, and the Kombucha Genomics project; or their Agar art workshop where you’ll design your own petri dish art using colorful bacteria like the ones below:
Check out the SynBioBeta 2018 schedule:

I hope you’ll join us!John

Scientists a step closer to developing a "synthetic microbiome"

Horizon Discovery announces collaboration on single cell RNAseq-linked CRISPR screening

Amyris gets green light for commercial sales of its new, natural, zero-calorie sweetener



Two CAR-T Cell therapies greenlighted in Europe

Gene editing of dogs offers hope for treating human muscular dystrophy


















